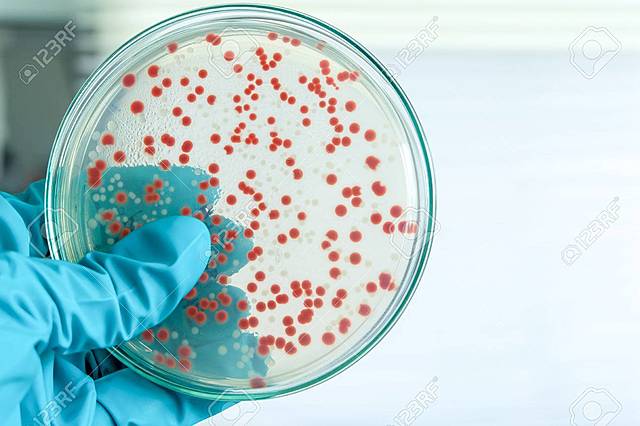
cibergrafia

-
Sara Gómez Muñoz
11 -
inventor del microscopio compuesto
compuesto por un tubo de 70 cm y 9 cm de diámetro -
se alude el nombre célula
-
desmonto la hipótesis de la generación espontanea
-
hallo los microorganismos a los que nombro "animalucos"
-
dio las primeras bases de la taxonomía moderna
-
dio su opinión sobre que el aire transporta germanes al medio de cultivo
-
crea técnicas de vacunación
desarrolla vacuna a la viruela -
separa el reino animal del vegetal y lo nombro metabolismo
-
se le atribuye la técnica conocida como "pasteurización"
-
descubridor de los antisépticos
-
crea un taxón el cual se nombro "moneres"
-
el pionero en aislar microorganismos
considerado el fundador de la bacteriología -
CONFIRMO LA TEORÍA DE "BIOGÉNESIS"
-
ayuda a la teoría de la inmunidad de cadena lateral
-
surgimiento del agar-agar
-
descubrió el proceso de "nitrificación"
-
desarrolla su método de tirocinio de bacterias
-
crea la placa petri
-
descubre la "penicilina"
-
crecimientos de "bacteriofagos"
-
descubre que el DAN es material genético
-
descubrieron la estructura molecular del DAN
-
clasifica de manera taxonómica
-
creo la nueva taxonomía molecular
-
Plan projects on a visual timeline
Map milestones, phases, deadlines, and key events in one place so the sequence is easier to see and share. Timetoast is a timeline maker for work, school, research, and stories.